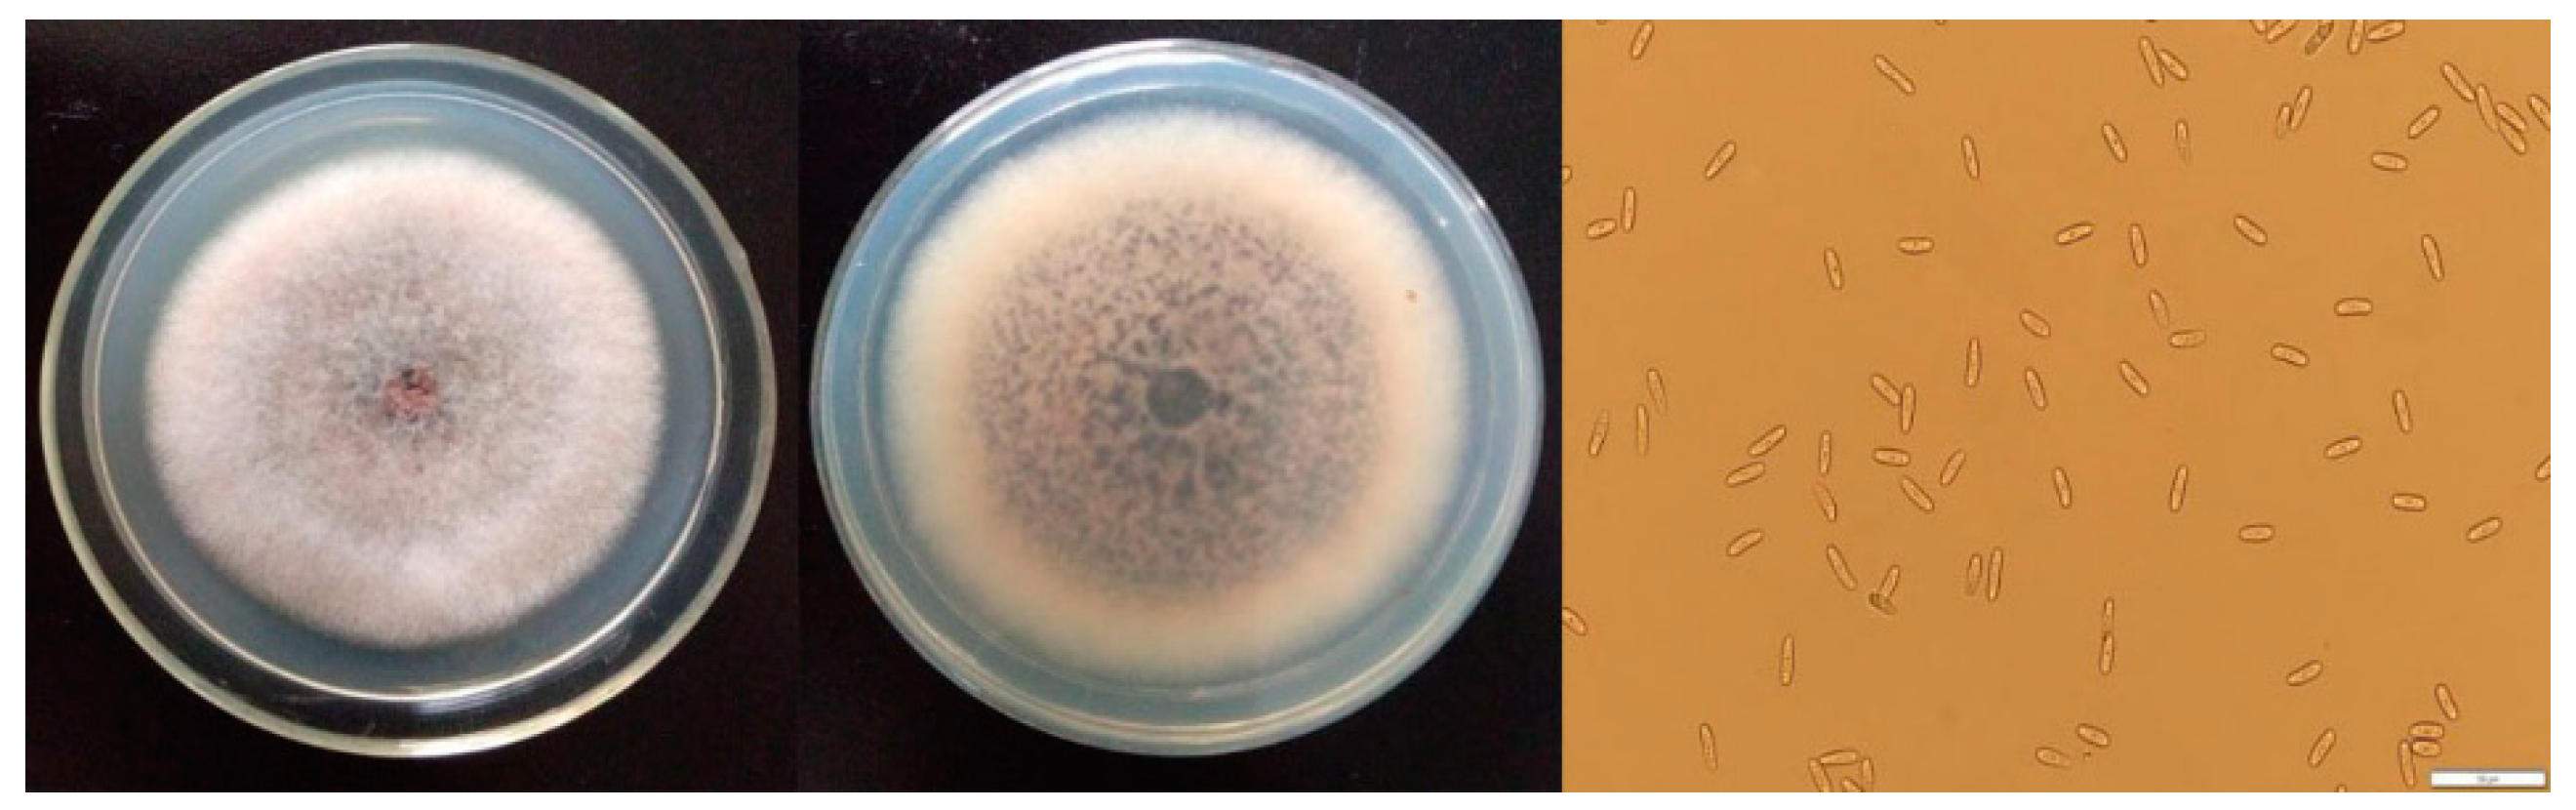
Molecules 24 03386 g001 Molecules 24 03386 g001
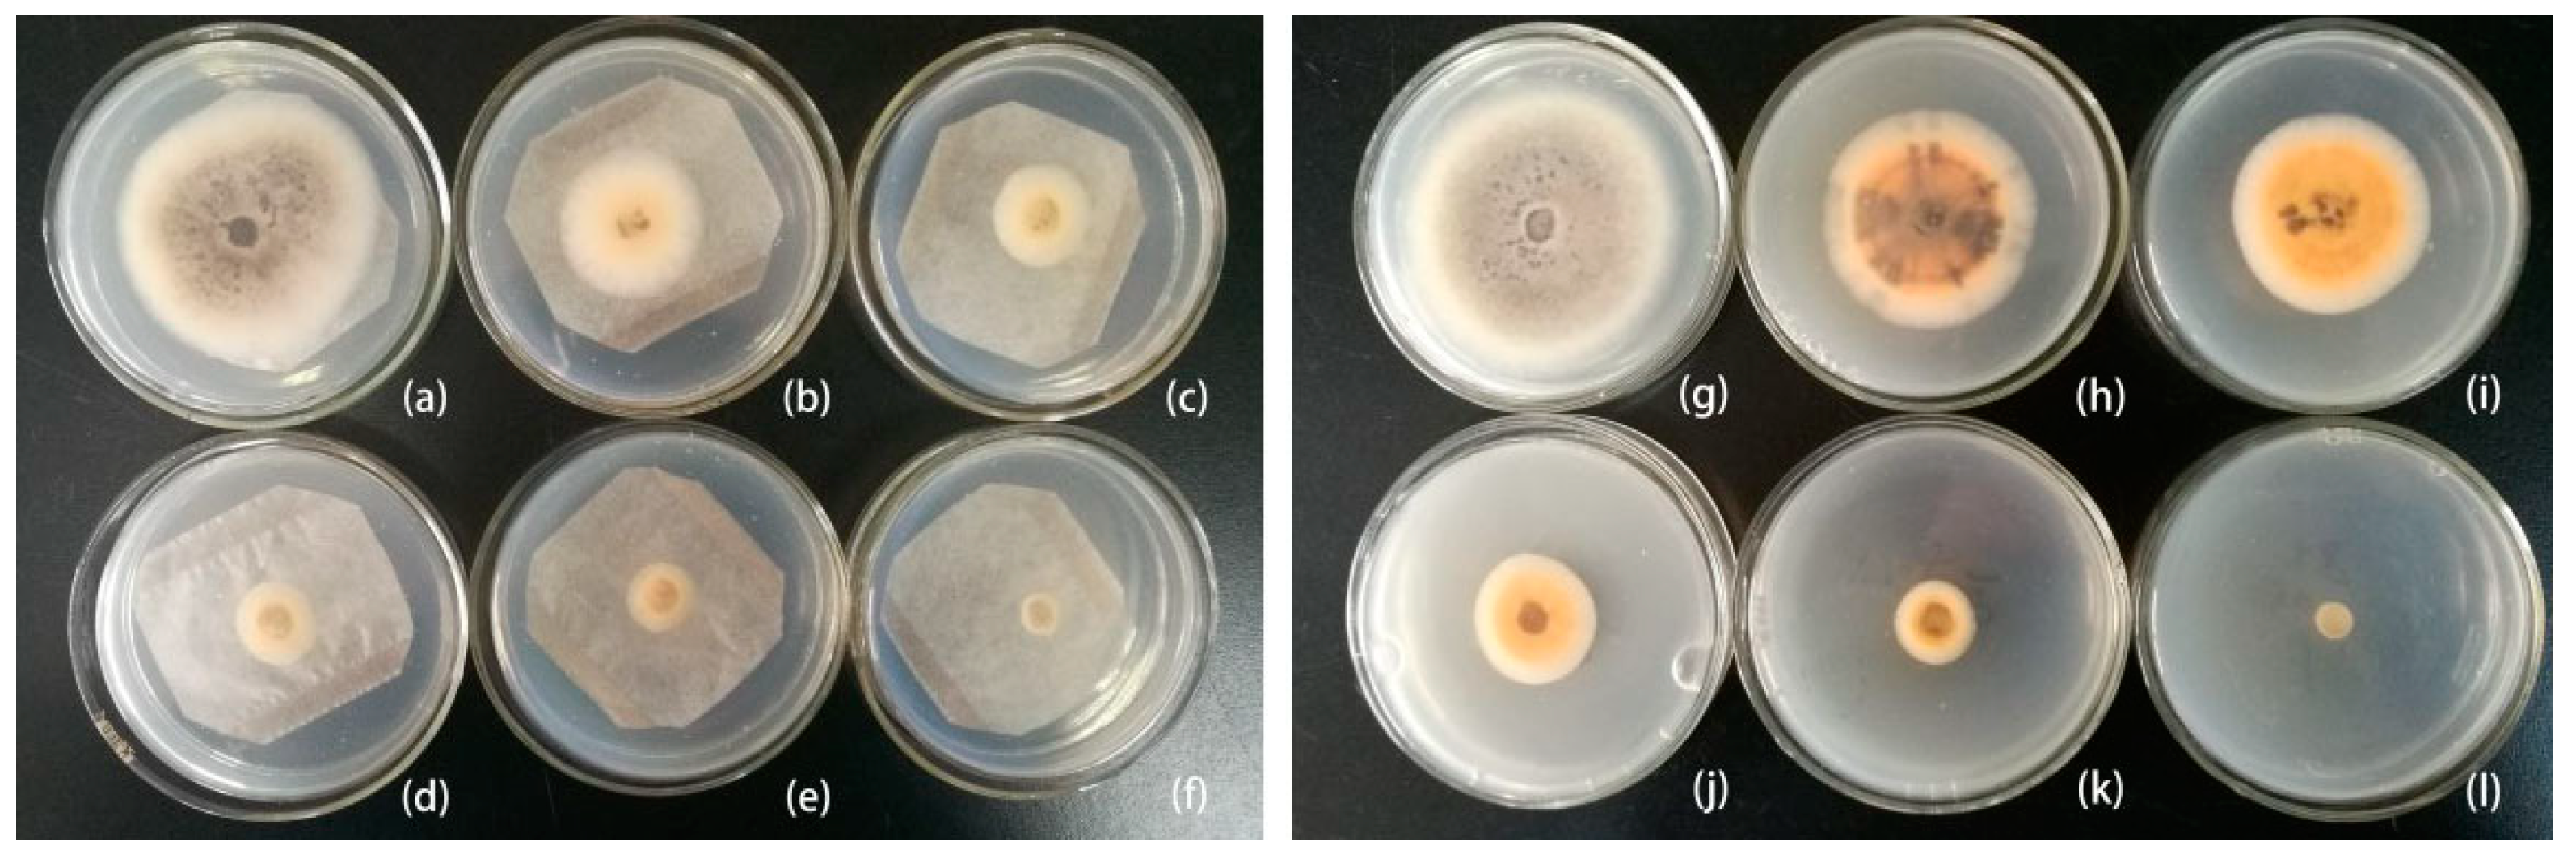
Molecules 24 03386 g004 Molecules 24 03386 g004

Antifungal Effects and Potential Mechanism of Essential Oils on Collelotrichum gloeosporioides In Vitro and In Vivo
Abstract
1. Introduction
2. Results and Discussion
2.1. The Morphological Characteristics of C. Gloeosporioides
2.2. Antimicrobial Effect of Essential Oils In Vitro
2.2.1. Antifungal Activity of Seven Essential Oils In Vitro
2.2.2. Chemical Composition and Antifungal Activity of Optimized Essential Oils In Vitro
2.3. The Control of Postharvest Fungal Decay of Sweet Cherries by Clove Oil In Vivo
2.3.1. Efficacy of Clove Oil on Natural Decay Development in Intact Sweet Cherry Fruits
2.3.2. Efficacy of Clove Oil on Rot Development in Artificially Inoculated Sweet Cherry Fruits
2.4. Observing the Effect of Clove Oil on Hyphal Morphology and Cellular Ultrastructure
2.5. Effect of Clove Oil on the Cell Wall and Cell Membrane
3. Materials and Methods
3.1. Sweet Cherries Fruits and Essential Oils
3.2. Chemical Composition of Essential Oils Analyzed by GC-MS
3.3. Fungi and Culture
3.4. Assessment of the Effect of Essential Oils on Mycelium Growth by Vapour and Contact Phase In Vitro
3.4.1. Fumigation Assay
3.4.2. Contact Assay
3.5. Control of Fungal Decay of Sweet Cherries by Clove Oil In Vivo
3.5.1. Effects of Clove Oil on Natural Infection Development in Intact Sweet Cherry Fruits
3.5.2. Effects of Clove Oil on Rot Development in Artificially Inoculated and Wounded Fruit
3.6. Scanning Electron Microscopy (SEM) and Transmission Electron Microscopy (TEM) of Hyphal Morphology and Cellular Ultrastructure
3.7. Assessment of the Effect of Clove Oil on the Cell Wall and Cell Membrane
3.8. Statistical Analyses
4. Conclusions
Author Contributions
Funding
Conflicts of Interest
References
- Chockchaisawasdee, S.; Golding, J.B.; Vuong, Q.V.; Papoutsis, K.; Stathopoulos, C.E. Sweet cherry: Composition, postharvest preservation, processing and trends for its future use. Trends Food Sci. Technol. 2016, 55, 72–83. [Google Scholar] [CrossRef]
- Alique, R.; Zamorano, J.P.; Martínez, M.A.; Alonso, J. Effect of heat and cold treatments on respiratory metabolism and shelf-life of sweet cherry, type picota cv “Ambrunés”. Postharvest Biol. Technol. 2005, 35, 153–165. [Google Scholar] [CrossRef]
- Habib, M.; Bhat, M.; Dar, B.N.; Wani, A.A. Sweet cherries from farm to table: A review. Crit. Rev. Food Sci. Nutr. 2017, 57, 1638–1649. [Google Scholar] [CrossRef] [PubMed]
- Børve, J.; Stensvand, A. Timing of fungicide applications against anthracnose in sweet and sour cherry production in Norway. Crop Prot. 2006, 25, 781–787. [Google Scholar] [CrossRef]
- Ippolito, A.; Nigro, F. Impact of preharvest application of biological control agents on postharvest diseases of fresh fruits and vegetables. Crop Prot. 2000, 19, 715–723. [Google Scholar] [CrossRef]
- Hu, Y.; Zhang, J.; Kong, W.; Zhao, G.; Yang, M. Mechanisms of antifungal and anti-aflatoxigenic properties of essential oil derived from turmeric (Curcuma longa L.) on Aspergillus flavus. Food Chem. 2017, 220, 1–8. [Google Scholar] [CrossRef] [PubMed]
- Kedia, A.; Prakash, B.; Mishra, P.K.; Dubey, N.K. Antifungal and antiaflatoxigenic properties of Cuminum cyminum (L.) seed essential oil and its efficacy as a preservative in stored commodities. Int. J. Food Microbiol. 2014, 168–169, 1–7. [Google Scholar] [CrossRef] [PubMed]
- López, A.; Castro, S.; Andina, M.J.; Ures, X.; Munguía, B.; Llabot, J.M.; Elder, H.; Dellacassa, E.; Palma, S.; Domínguez, L. Insecticidal activity of microencapsulated Schinus molle essential oil. Ind. Crop. Prod. 2014, 53, 209–216. [Google Scholar] [CrossRef]
- Requena, R.; Vargas, M.; Chiralt, A. Study of the potential synergistic antibacterial activity of essential oil components using the thiazolyl blue tetrazolium bromide (MTT) assay. LWT 2019, 101, 183–190. [Google Scholar] [CrossRef]
- Vilaplana, R.; Pazmiño, L.; Valencia-Chamorro, S. Control of anthracnose, caused by Colletotrichum musae, on postharvest organic banana by thyme oil. Postharvest Biol. Technol. 2018, 138, 56–63. [Google Scholar] [CrossRef]
- Bill, M.; Sivakumar, D.; Korsten, L.; Thompson, A.K. The efficacy of combined application of edible coatings and thyme oil in inducing resistance components in avocado (Persea americana Mill.) against anthracnose during post-harvest storage. Crop Prot. 2014, 64, 159–167. [Google Scholar] [CrossRef]
- de Oliveira, K.Á.R.; Berger, L.R.R.; de Araújo, S.A.; Câmara, M.P.S.; de Souza, E.L. Synergistic mixtures of chitosan and Mentha piperita L. essential oil to inhibit Colletotrichum species and anthracnose development in mango cultivar Tommy Atkins. Food Microbiol. 2017, 66, 96–103. [Google Scholar] [CrossRef]
- Boonruang, K.; Kerddonfag, N.; Chinsirikul, W.; Mitcham, E.J.; Chonhenchob, V. Antifungal effect of poly (lactic acid) films containing thymol and R-(-)-carvone against anthracnose pathogens isolated from avocado and citrus. Food Control 2017, 78, 85–93. [Google Scholar] [CrossRef]
- Børve, J.; Stensvand, A. Non-abscised aborted sweet cherry fruits are vulnerable to fruit decaying fungi and may be sources of infection for healthy fruits. Acta Agric. Scand. B-Soil Plant Sci. 2004, 54, 31–37. [Google Scholar] [CrossRef]
- Weir, B.S.; Johnston, P.R.; Damm, U. The Colletotrichum gloeosporioides species complex. Stud. Mycol. 2012, 73, 115–180. [Google Scholar] [CrossRef] [PubMed]
- Inouye, S.; Tsuruoka, T.; Watanabe, M.; Takeo, K.; Akao, M.; Nishiyama, Y.; Yamaguchi, H. Inhibitory effect of essential oils on apical growth of Aspergillus fumigatus by vapour contact. Mycoses 2000, 43, 17–23. [Google Scholar] [CrossRef] [PubMed]
- Sellamuthu, P.S.; Sivakumar, D.; Soundy, P.; Korsten, L. Essential oil vapours suppress the development of anthracnose and enhance defence related and antioxidant enzyme activities in avocado fruit. Postharvest Biol. Technol. 2013, 81, 66–72. [Google Scholar] [CrossRef]
- Bill, M.; Korsten, L.; Remize, F.; Glowacz, M.; Sivakumar, D. Effect of thyme oil vapours exposure on phenylalanine ammonia-lyase (PAL) and lipoxygenase (LOX) genes expression, and control of anthracnose in ‘Hass’ and ‘Ryan’ avocado fruit. Sci. Hortic. 2017, 224, 232–237. [Google Scholar] [CrossRef]
- Bill, M.; Sivakumar, D.; Beukes, M.; Korsten, L. Expression of pathogenesis-related (PR) genes in avocados fumigated with thyme oil vapours and control of anthracnose. Food Chem. 2016, 194, 938–943. [Google Scholar] [CrossRef]
- Combrinck, S.; Regnier, T.; Kamatou, G.P.P. In vitro activity of eighteen essential oils and some major components against common postharvest fungal pathogens of fruit. Ind. Crop. Prod. 2011, 33, 344–349. [Google Scholar] [CrossRef]
- Hong, J.K.; Yang, H.J.; Jung, H.; Yoon, D.J.; Sang, M.K.; Jeun, Y.-C. Application of Volatile Antifungal Plant Essential Oils for Controlling Pepper Fruit Anthracnose by Colletotrichum gloeosporioides. Plant Pathol. J. 2015, 31, 269–277. [Google Scholar] [CrossRef] [PubMed]
- Imelouane, B.; Hassan, A.; Wathelet, J.P.; Ankit, M.; Khedid, K.; El Bachiri, A. Chemical composition and antimicrobial activity of essential oil of thyme (Thymus vulgaris) from Eastern Morocco. Int. J. Agric. Biol. 2009, 11, 205–208. [Google Scholar]
- Charai, M.; Mosaddak, M.; Faid, M. Chemical Composition and Antimicrobial Activities of Two Aromatic Plants: Origanum majorana L. and O. compactum Benth. J. Essent. Oil Res. 1996, 8, 657–664. [Google Scholar] [CrossRef]
- Becerril, R.; Gómez-Lus, R.; Goñi, P.; López, P.; Nerín, C. Combination of analytical and microbiological techniques to study the antimicrobial activity of a new active food packaging containing cinnamon or oregano against E. coli and S. aureus. Anal. Bioanal. Chem. 2007, 388, 1003–1011. [Google Scholar] [CrossRef] [PubMed]
- Ju, J.; Xu, X.; Xie, Y.; Guo, Y.; Cheng, Y.; Qian, H.; Yao, W. Inhibitory effects of cinnamon and clove essential oils on mold growth on baked foods. Food Chem. 2018, 240, 850–855. [Google Scholar] [CrossRef] [PubMed]
- Feng, W.; Chen, J.; Zheng, X.; Liu, Q. Thyme oil to control Alternaria alternata in vitro and in vivo as fumigant and contact treatments. Food Control. 2011, 22, 78–81. [Google Scholar] [CrossRef]
- Lehtijärvi, H.T.D. Antifungal effect of essential oils from some Turkish herbs against Rhizoctonia solani Kühn. Phytopathol. Mediterr. 2006, 45, 261–265. [Google Scholar]
- Sivakumar, D.; Bautista-Baños, S. A review on the use of essential oils for postharvest decay control and maintenance of fruit quality during storage. Crop. Prot. 2014, 64, 27–37. [Google Scholar] [CrossRef]
- Arras, G.; Usai, M. Fungitoxic Activity of 12 Essential Oils against Four Postharvest Citrus Pathogens: Chemical Analysis of Thymus capitatus Oil and its Effect in Subatmospheric Pressure Conditions. J. Food Prot. 2001, 64, 1025–1029. [Google Scholar] [CrossRef]
- Lopez-Reyes, J.G.; Spadaro, D.; Gullino, M.L.; Garibaldi, A. Efficacy of Plant Essential Oils on Postharvest Control of Rots Caused by Fungi on Different Stone Fruits In Vivo. Flavour Frag. J. 2010, 25, 171–177. [Google Scholar] [CrossRef]
- Grande-Tovar, C.D.; Chaves-Lopez, C.; Serio, A.; Rossi, C.; Paparella, A. Chitosan coatings enriched with essential oils: Effects on fungi involved in fruit decay and mechanisms of action. Trends Food Sci. Technol. 2018, 78, 61–71. [Google Scholar] [CrossRef]
- Liu, Q.-R.; Wang, W.; Qi, J.; Huang, Q.; Xiao, J. Oregano essential oil loaded soybean polysaccharide films: Effect of Pickering type immobilization on physical and antimicrobial properties. Food Hydrocolloid. 2019, 87, 165–172. [Google Scholar] [CrossRef]
- Paul, S.; Dubey, R.C.; Maheswari, D.K.; Kang, S.C. Trachyspermum ammi (L.) fruit essential oil influencing on membrane permeability and surface characteristics in inhibiting food-borne pathogens. Food Control 2011, 22, 725–731. [Google Scholar] [CrossRef]
- da Silva Bomfim, N.; Nakassugi, L.P.; Oliveira, J.F.P.; Kohiyama, C.Y.; Mossini, S.A.G.; Grespan, R.; Nerilo, S.B.; Mallmann, C.A.; Alves Abreu Filho, B.; Machinski, M. Antifungal activity and inhibition of fumonisin production by Rosmarinus officinalis L. essential oil in Fusarium verticillioides (Sacc.) Nirenberg. Food Chem. 2015, 166, 330–336. [Google Scholar] [CrossRef] [PubMed]
- Cristani, M.; D’Arrigo, M.; Mandalari, G.; Castelli, F.; Sarpietro, M.G.; Micieli, D.; Venuti, V.; Bisignano, G.; Saija, A.; Trombetta, D. Interaction of four monoterpenes contained in essential oils with model membranes: Implications for their antibacterial activity. J. Agric. Food Chem. 2007, 55, 6300–6308. [Google Scholar] [CrossRef] [PubMed]
- Burt, S. Essential oils: Their antibacterial properties and potential applications in foods—A review. Int. Food Microbiol. 2004, 94, 223–253. [Google Scholar] [CrossRef] [PubMed]
- Zeng, L.-B.; Zhang, Z.-R.; Luo, Z.-H.; Zhu, J.-X. Antioxidant activity and chemical constituents of essential oil and extracts of Rhizoma Homalomenae. Food Chem. 2011, 125, 456–463. [Google Scholar] [CrossRef]
Sample Availability: Samples of the compounds are available from the authors. |

| Essential Oils | Rate of Mycelial Inhibition/% | |
|---|---|---|
| Vapour Phase (100 μL/L) | Contact Phase (1000 μL/L) | |
| Clove Engenia caryophyllus | 100 ± 0.00 a | 100 ± 0.00 a |
| Thyme Thymus serpyllum | 73.24 ± 0.17 b | 85.43 ± 0.05 b |
| Palmarosa Cymbopogon martinii | 39.44 ± 0.13 c | 66.23 ± 0.32 c |
| Lemongrass Cymbopogon citratus | 44.37 ± 0.18 c | 40.40 ± 0.24 d |
| Lemon Citrus limonum | 3.52 ± 0.08 e | 11.35 ± 0.11 e |
| Cinnamon Cinnamomum cassia | 100 ± 0.00 a | 100 ± 0.00 a |
| Laurel leaf Laurus nobilis | 33.80 ± 0.10 d | 37.59 ± 0.08 d |
| Peak No. | RT/min | Compounds | Content (%) |
|---|---|---|---|
| Clove oil | |||
| 1 | 10.261 | Eugenol | 78.952 |
| 2 | 11.246 | β-caryophyllene | 2.149 |
| 3 | 11.713 | α- caryophyllene | 7.261 |
| 4 | 12.336 | Eugenol acetate | 17.892 |
| 5 | 13.311 | Oxetene | 0.281 |
| Cinnamon oil | |||
| 1 | 4.426 | Terpene | 0.957 |
| 2 | 4.578 | Benzaldehyde | 26.805 |
| 3 | 5.476 | 4-isopropyltoluene | 0.486 |
| 4 | 5.550 | Limonene | 0.060 |
| 5 | 5.606 | Amine leaf alcohol | 0.102 |
| 6 | 5.791 | Salicylaldehyde | 3.260 |
| 7 | 6.639 | Furfural | 0.032 |
| 8 | 7.737 | 2-propanol | 0.406 |
| 9 | 8.687 | O-methoxybenzaldehyde | 0.083 |
| 10 | 8.875 | Phenylacetate | 0.480 |
| 11 | 8.999 | Trans-2-nonenal | 0.036 |
| 12 | 9.214 | Trans-cinnamaldehyde | 67.247 |
| 13 | 9.830 | 2,4-nonadienal | 0.038 |
| 14 | 10.414 | 2-undecenal | 0.011 |
| Treatments | Virulence Regression Equation | EC50 (μL/L) | MIC (μL/L) |
|---|---|---|---|
| Clove oil-vapour phase | Y = 0.8677X + 32.508 R2 = 0.9643 | 20 | 80 |
| Cinnamon oil-vapour phase | Y = 1.2975X − 26.775 R2 = 0.9913 | 59 | 100 |
| Clove oil-contact phase | Y = 0.2482X + 25.147 R2 = 0.9992 | 100 | 300 |
| Cinnamon oil-contact phase | Y = 0.3867X − 23.193 R2 = 0.9062 | 189 | 300 |
© 2019 by the authors. Licensee MDPI, Basel, Switzerland. This article is an open access article distributed under the terms and conditions of the Creative Commons Attribution (CC BY) license (http://creativecommons.org/licenses/by/4.0/).
Share and Cite
Wang, D.; Zhang, J.; Jia, X.; Xin, L.; Zhai, H. Antifungal Effects and Potential Mechanism of Essential Oils on Collelotrichum gloeosporioides In Vitro and In Vivo. Molecules 2019, 24, 3386. https://doi.org/10.3390/molecules24183386
Wang D, Zhang J, Jia X, Xin L, Zhai H. Antifungal Effects and Potential Mechanism of Essential Oils on Collelotrichum gloeosporioides In Vitro and In Vivo. Molecules. 2019; 24(18):3386. https://doi.org/10.3390/molecules24183386
Chicago/Turabian StyleWang, Dan, Jing Zhang, Xiaoman Jia, Li Xin, and Hao Zhai. 2019. "Antifungal Effects and Potential Mechanism of Essential Oils on Collelotrichum gloeosporioides In Vitro and In Vivo" Molecules 24, no. 18: 3386. https://doi.org/10.3390/molecules24183386
APA StyleWang, D., Zhang, J., Jia, X., Xin, L., & Zhai, H. (2019). Antifungal Effects and Potential Mechanism of Essential Oils on Collelotrichum gloeosporioides In Vitro and In Vivo. Molecules, 24(18), 3386. https://doi.org/10.3390/molecules24183386





